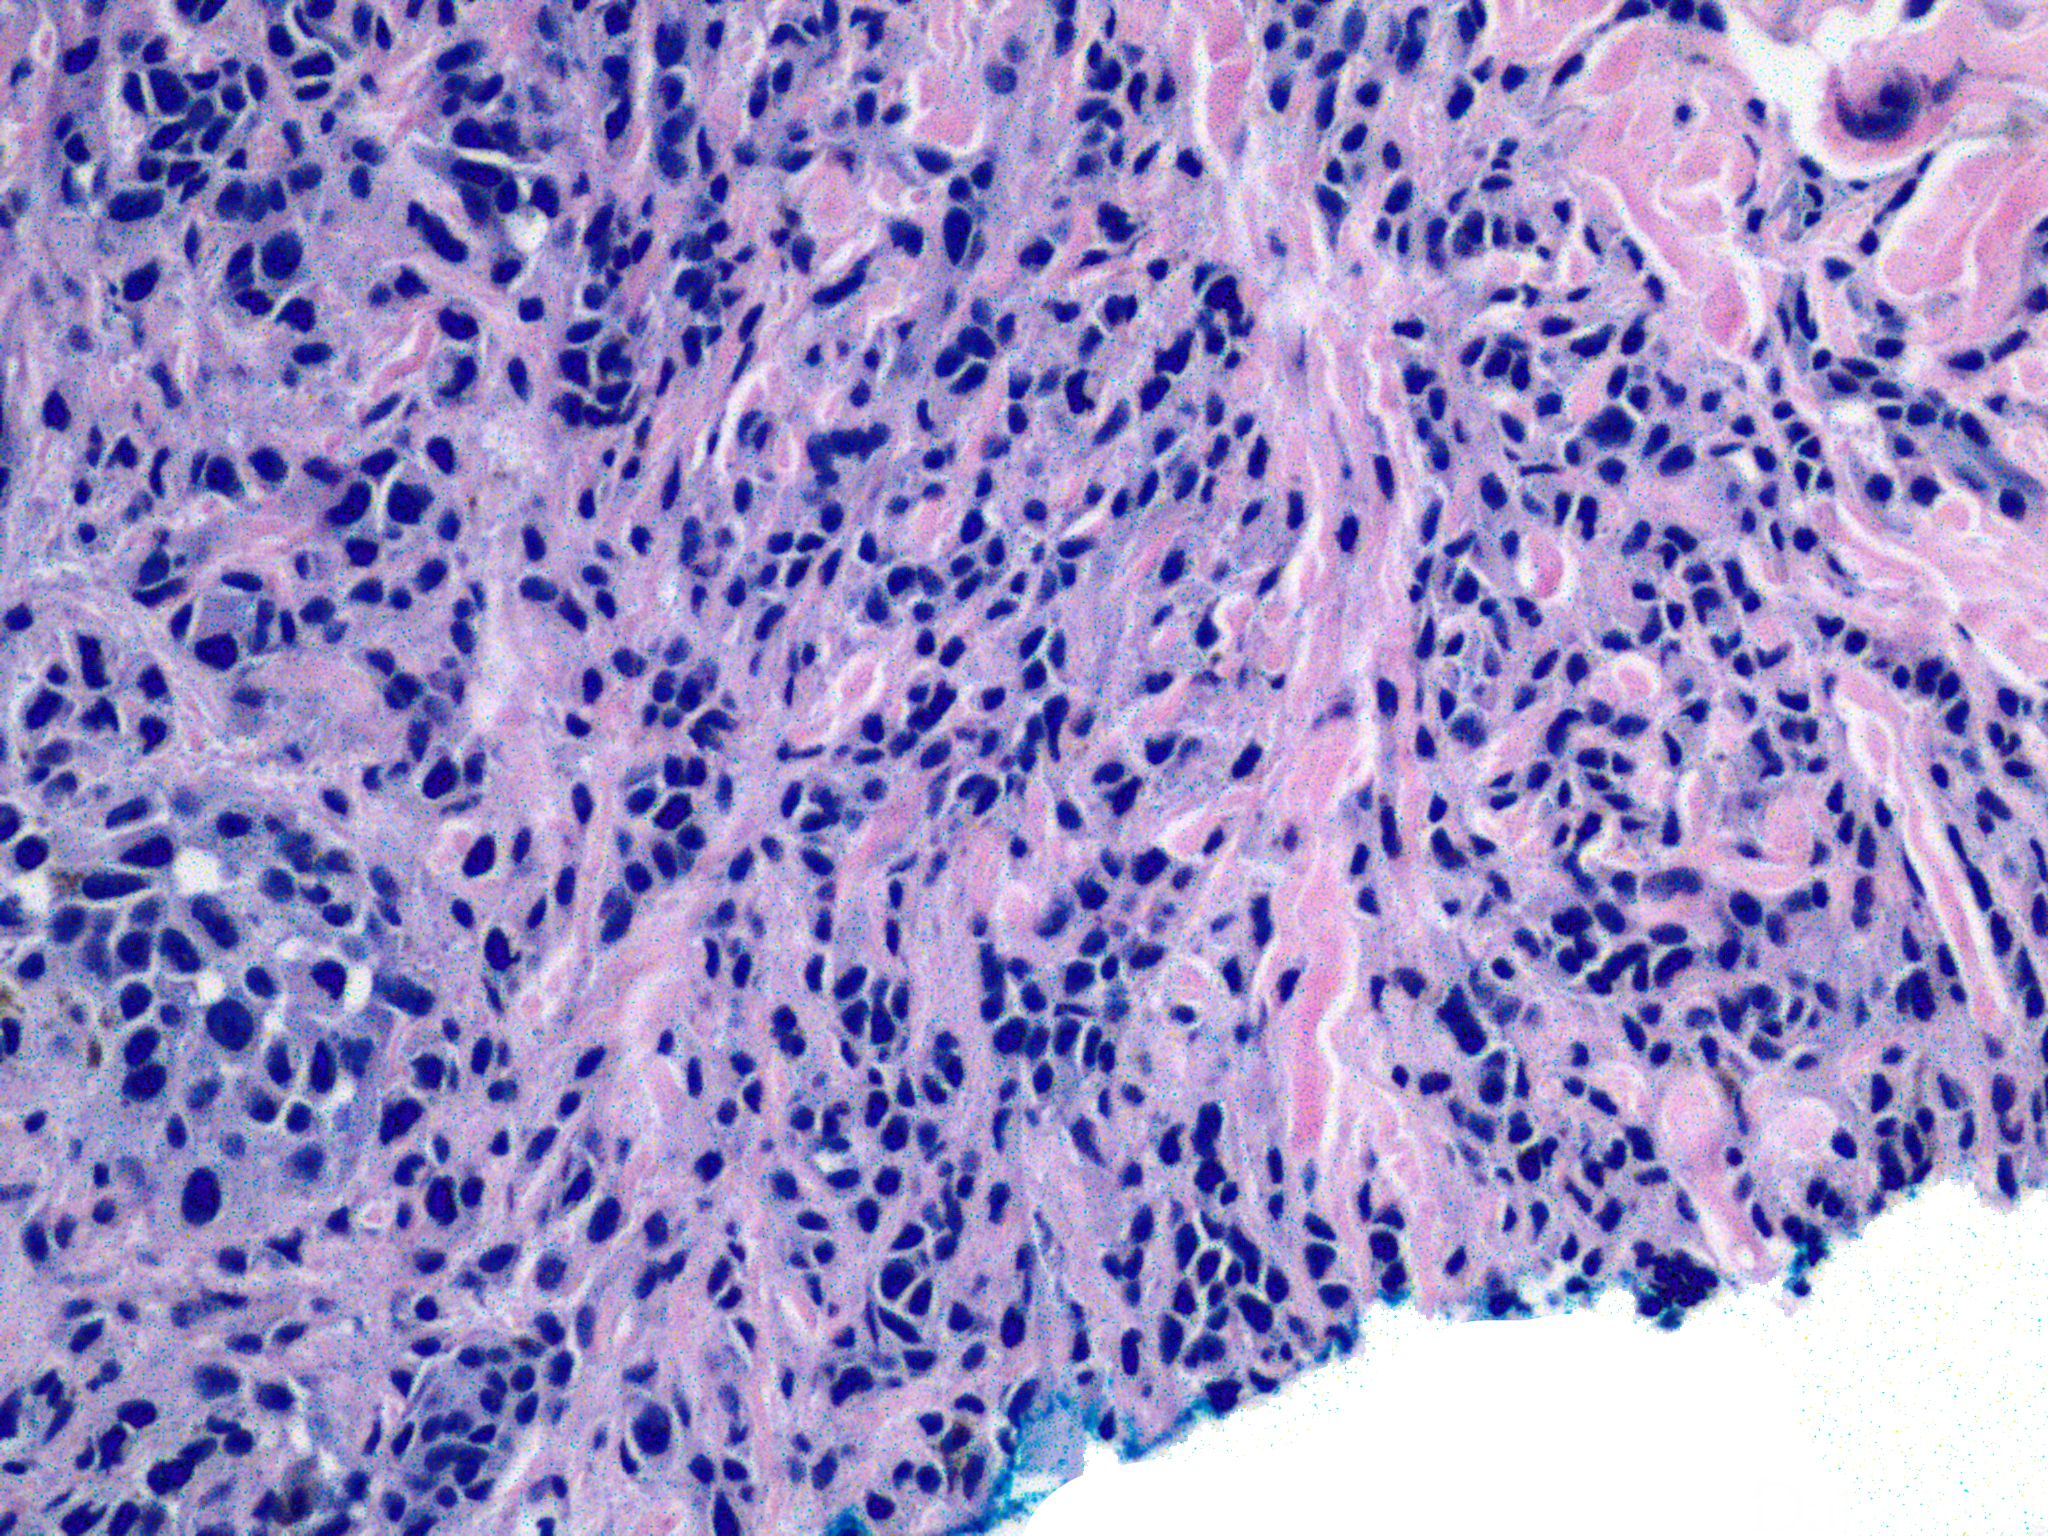

结节性黑色素瘤
Nodular Melanoma
概述:
黑色素瘤的一个亚型,早期呈垂直方式生长
发病部位: 全身体表均可发病,以躯干和腿部多见
诊断要点:
多见于中老年,平均发病年龄 63 岁,全身体表均可发病,以躯干和腿部多见,颜色多样,呈结节状或息肉状,周边常呈黑色斑点状;
无水平(放射状)生长期,早期即呈垂直生长方式;
真皮内见肿瘤细胞呈黏附性结节状增生,具推进型边缘;
细胞通常为上皮样,也可能呈梭形或小细胞型,偶尔可见大细胞型;
表皮薄,可伴有溃疡;
常无原位黑色素瘤成分。

← 雀斑样黑色素瘤 促结缔组织增生性黑色素瘤 →
